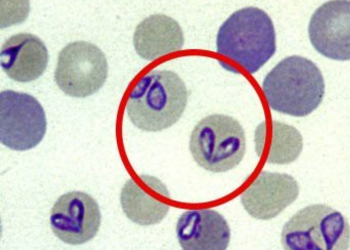

La piroplasmose équine est une maladie parasitaire qui affecte les chevaux et autres équidés comme les mules, ânes et zèbres. Cette maladie du sang, due à des protozoaires du genre Babesia et Theileria, est transmise par la morsure de tiques vectrices.
La piroplasmose chez le cheval a un réel impact sanitaire et économique, ce qui en fait une préoccupation majeure, notamment dans les régions où les tiques sont endémiques. Elle est particulièrement répandue dans le sud de la France, en Europe méridionale, en Afrique, en Asie et dans les zones subtropicales.
L’importance de la piroplasmose équine réside dans ses effets potentiellement graves : anémie, fatigue, voire mort des animaux non traités. Sa forme aiguë peut entraîner une destruction rapide des globules rouges, tandis que sa forme chronique affaiblit progressivement l’animal infecté.
Les chevaux atteints nécessitent une prise en charge rapide et adaptée pour éviter des complications graves. De plus, la propagation de la maladie, souvent liée à l’importation de chevaux infectés, représente un risque spécifique pour les territoires jusque-là épargnés. Nous allons donc aborder cette maladie en détails, de son origine à ses signes cliniques en passant par la gestion des cas infectés.
Origine de la piroplasmose équine
Une maladie parasitaire : Babesia caballi et Theileria equi
La piroplasmose équine est une infection parasitaire causée par deux types de protozoaires :
🟠 Babesia caballi : provoque des infections généralement moins sévères
🟠 Theileria equi : associé à des symptômes plus graves et des infections chroniques
Ces protozoaires se multiplient dans les globules rouges du cheval, entraînant leur destruction (ou hémolyse) et provoquant des symptômes comme une anémie, un ictère (coloration jaune des muqueuses due à la destruction des hématies, avec accumulation d’un déchet : la bilirubine), et une fatigue généralisée.
Chaque genre de parasite agit différemment sur le système sanguin, mais tous deux ont un impact sur la santé des chevaux en affaiblissant leur système immunitaire et en perturbant les fonctions vitales.
Mode de transmission de la maladie
Le principal vecteur de la piroplasmose chez le cheval est la tique, en particulier celles du genre Dermacentor. Lors de leur repas de sang, ces tiques infectées transmettent les protozoaires dans le sang du cheval. La contamination se fait par :
🟠 Morsure directe : Les tiques ingèrent les protozoaires lors de leurs précédents repas sur un animal infecté et les transmettent ensuite à un cheval sain.
🟠 Transmission transplacentaire : Une jument infectée peut transmettre la maladie à son poulain durant la gestation.
🟠 Transfusions sanguines : Une transfusion provenant d’un cheval porteur peut provoquer une contamination.
Signes cliniques et méthodes de diagnostic
Symptômes cliniques
Les symptômes cliniques de la piroplasmose chez le cheval varient en fonction de la forme (aiguë ou chronique) et de la gravité de l’infection :
Forme aiguë :
- Fièvre élevée (souvent supérieure à 40°C).
- Fatigue marquée et abattement.
- Ictère = coloration jaune des muqueuses.
- Anémie due à la destruction des globules rouges.
- Perte de poids rapide et diminution de l’appétit.
- Engorgement des membres et parfois douleurs musculaires.
Forme chronique :
- Symptômes moins visibles, mais une fatigue persistante, une perte de poids et des troubles immunitaires voir une légère anémie
Dans les deux cas, un cheval atteint peut devenir un porteur chronique, capable de transmettre la maladie.
Méthodes de diagnostic
Le diagnostic de la piroplasmose équine nécessite des examens spécifiques pour détecter la présence des parasites dans le sang ou des signes indirects de sa présence :
1. Observation microscopique : Analyse d’un frottis sanguin coloré pour détecter les parasites dans les hématies.
2. Sérologie : Recherche des anticorps produits par le système immunitaire du cheval en réponse à l’infection par le parasite.
3. Test PCR : Permet de confirmer la présence de Babesia caballi ou Theileria equi
4. Signes cliniques : Prise en compte des symptômes tels que l’anémie, l’ictère, et les signes d’abattement.
Un conseil vétérinaire est indispensable pour choisir la méthode diagnostique adaptée et éviter les erreurs.
Traitement et moyens de prévention
Traitements médicamenteux
Le traitement de la piroplasmose repose sur l’utilisation de médicaments spécifiques prescrit par votre vétérinaire, pour éliminer les protozoaires et atténuer les symptômes cliniques :
🟠 Imidocarbe dipropionate : Le traitement le plus courant pour éradiquer Babesia caballi et Theileria equi. Ce médicament antiparasitaire est administré par injection.
🟠 Soutien immunitaire : Utilisation de compléments alimentaires riches en vitamines et minéraux pour renforcer le système immunitaire et favoriser la récupération.
🟠 Soins symptomatiques : Anti-inflammatoires et mesures pour prévenir les complications.
🟠 Soutien nutritionnel : des compléments riches en oligo-éléments et vitamines afin de faciliter la reconstitution du stock de globules rouges peut également être prescrit au cheval afin de faciliter la récupération.
Le suivi par un vétérinaire est essentiel pour surveiller la réponse au traitement et éviter les récidives.
Prévenir l’apparition et les récidives de la maladie
La prévention de la piroplasmose équine repose sur un contrôle efficace des tiques vectrices et des pratiques sanitaires rigoureuses :
Contrôle des tiques :
- Retrait manuel des tiques à l’aide d’un tire-tique pour éviter leur propagation.
Soutien nutritionnel :
- Des compléments pour renforcer son système immunitaire peuvent être administrés, de même que des compléments pour le soutien de l’effort riches en oligo-éléments et vitamines (comme les CMV cheval) pour essayer de limiter les récidives.
Vous l’aurez donc compris, la piroplasmose équine est une maladie parasitaire complexe qui représente une menace sérieuse pour les équidés dans les régions où les tiques vectrices sont présentes.
Sa prise en charge nécessite une approche spécifique basée sur une prévention rigoureuse, un diagnostic précis et un traitement spécifique sous la supervision d’un vétérinaire.
Les efforts pour limiter la propagation de la maladie doivent inclure des mesures sanitaires adaptées et une vigilance accrue, en particulier lors des déplacements internationaux des chevaux.